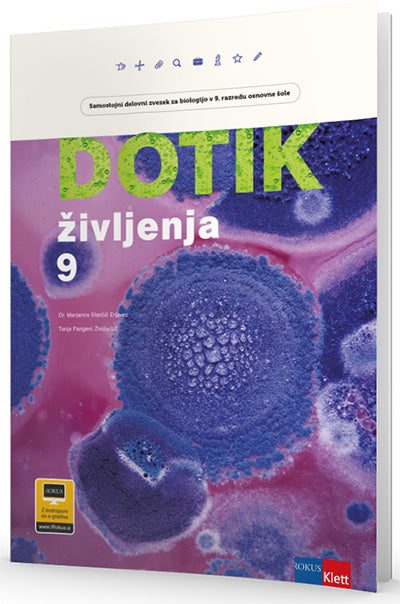

DOTIK ŽIVLJENJA 9, samostojni delovni zvezek za biologijo v 9. razredu osnovne šole
DOTIK ŽIVLJENJA 9 - SDZ
samostojni delovni zvezek za biologijo

MARJANCA STARČIČ ERJAVECTANJA PANGERC ŽNIDARŠIČ
DOTIK ŽIVLJENJA 9 - SDZ
samostojni delovni zvezek za biologijo
Zaloga po trgovinah
Rezultati:
Podrobnosti o izdelku
Poglej vseISBN
9789612920173Mladinska knjiga ID
805860Leto izida
2020Datum izida
29.04.2020Velikost (šxdxv)
210 × 298 × 9Status dobavljivosti
6-7 delovnih dniJezik
SLOZaložnik
ZALOŽBA ROKUS KLETT, D.O.O.Avtor
MARJANCA STARČIČ ERJAVEC, TANJA PANGERC ŽNIDARŠIČOpis
Samostojni delovni zvezek Dotik življenja za 9. razred je prenovljeno in nadgrajeno gradivo iz serije Dotik življenja. Tako kot pripadajoči učbenik tudi samostojni delovni zvezek temelji na pristopu raziskovalnega učenja ter učence spodbuja k odkrivanju zakonitosti narave in bioloških procesov. Vključuje vse nujne informacije in definicije, napisane na preprost, učencem razumljiv način, ter veliko raznovrstnih nalog za utrjevanje usvojenega znanja pri pouku ali doma.
Odlike novega samostojnega delovnega zvezka:
• Vsako poglavje se začne z razlago učnih vsebin, ki je nazorna, stvarna in jasna. Razlage so usklajene z učnimi cilji in so nato predstavljene v nalogah. Tako učenci ponovijo že usvojeno znanje in se lahko posvetijo reševanju nalog.
• Naloge so različnih tipov in težavnostnih stopenj. Vključene so tudi dejavnosti, ki spodbujajo izkustveno učenje in raziskovanje.
• Na koncu vsakega poglavja je v rubriki Povzetek zapisan strnjen pregled snovi, ki zajema vse cilje učnega načrta. Povzetku sledijo miselni vzorci, povezani z vsebino posameznega poglavja.
• Razlage ključnih pojmov, navedene v slovarčku na koncu samostojnega delovnega zvezka, omogočajo preverjanje razumevanja snovi in utrjevanje znanja.
• Premišljena oblikovna podoba upošteva posamezna priporočila za oblikovanje gradiv za učence s specifičnimi učnimi težavami (npr. z disleksijo).
• Samostojni delovni zvezek je sestavljen tako, da omogoča formativno spremljanje in vrednotenje znanja.
Na www.iRokus.si je na voljo tudi elektronska verzija samostojnega delovnega zvezka, opremljena z vrhunskimi interaktivnimi dodatki: videoposnetki, animacijami in 3D-modeli človeškega telesa. Vanjo so vključene tudi rešitve nalog.
Pogosto kupljeno skupaj

Broširana
Ostali so si ogledali tudi ...

Več kot pol milijona knjig
Največja ponudba slovenskih in tujih knjig na enem mestu.

Enostaven nakup
Do izbranega le z nekaj kliki na spletu ali v eni od več kot 50 knjigarn.
Strokoven nasvet
Pred nakupom nas pokličite za nasvet ali se oglasite v knjigarni.

Vse za šolo
Nagrajena izobraževalna gradiva in kakovostne potrebščine.

Celovita ponudba za dom in pisarno
Vrhunski izdelki priznanih blagovnih znamk.
Brezplačna dostava
Brezplačna dostava za vsa naročila nad 59 € (za šolske pakete nad 140 €)
Knjigarne
Zaloga
×Osveženo 26.03.2023 10:09

Slovenska cesta 29, 1000 Ljubljana
E-naslovSpletna knjigarna: info@emka.si, Mladinska knjiga Založba: info@mladinska-knjiga.si
Kontakt01 241 30 00
Brezplačna številka080 12 05
Prijava na e-novice
© 2025 Mladinska knjiga. Vse pravice pridržane.
- Ko izberete elemente, se celotna stran osveži.
- Odpre se v novem oknu.